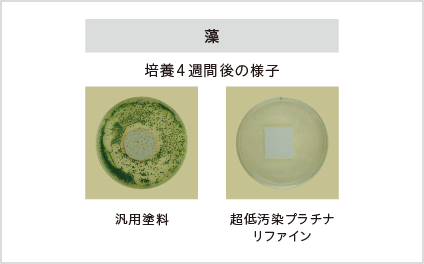

スタッフブログ
【大牟田市 外壁・屋根塗装】超低汚染プラチナリファイン2000MF-IRの魅力を徹底解説!!
2025.10.21
スタッフブログ
*…*…*…*…*…*…*…*…*…*…*…*…*…*…*…*
大牟田市の外壁・屋根塗装工事は
是非リペイントラボへご相談ください✨
*…*…*…*…*…*…*…*…*…*…*…*…*…*…*…*
大牟田市、荒尾市、みやま市、柳川市、大川市、玉名市にお住まいの皆様、こんにちは(^^♪
大牟田市地域密着の塗装専門店 プロタイムズ大牟田店(リペイントラボ)です。
住まいの“美しさ”と“安心”を長く保つために
外壁塗装を検討するとき、多くの方が重視するのは「見た目がきれいであること」「塗り替えの頻度が少ないこと」「劣化しにくいこと」です。
特に都市部・沿岸部・交通量の多い環境などでは、紫外線・雨・排気ガス・塩害など外的な劣化因子が多く、従来の塗料では数年で色褪せ・汚れ・藻・カビといった症状が現れてしまいがち。
そこで注目されているのが、アステックペイントが打ち出す「超低汚染」「高耐候性」「遮熱」などの高付加価値機能を備えた塗料です。
なかでもプラチナリファインMF-IRは、家を長期間、美しく、安心して保つための選択肢として非常に魅力的な一品です。
プラチナリファインMF-IRの立ち位置
プラチナリファインシリーズは、アステックペイントにおける最高級ライン。
耐候性・低汚染性・遮熱性・防カビ・防藻性など複数の機能が極めて高い次元で融合されています。
なかでもMF-IRにおいては、フッ素樹脂をベースに無機成分を重ねた“無機複合ハイブリット構造”を採用し、期待耐用年数はなんと21~26年という試験値を打ち出しています。
※ただし、実際の環境・施工・下地状態・気候・メンテナンス状況などにより、実耐用年数異なります。
主な機能&特徴
◎高耐候性
紫外線・風雨・環境ストレスに対して優れた耐性を持ちます。
プラチナリファインMF-IRでは「完全交互結合型フッ素樹脂」+「無機成分(特殊強化剤)」を樹脂構造に組み込むことで、紫外線などによる劣化が起こりにくい設計となっています。
また、促進耐候性試験(キセノンランプ式)では約21~26年相当後でも光沢保持率80%以上というデータがあります。

このような耐候性は、「塗ってすぐきれい」だけでなく「塗ってからもきれい」を目指す住宅にとって大きな強みです。
◎超低汚染性
汚れが付きにくく、付いても落ちやすい塗膜を実現しています。
具体的には、無機成分を配合することで塗膜を「緻密に」し、さらに「親水性」を持たせることで、付着した汚れが雨水で自然に洗い流されやすく設計されています。
塗膜の隙間に汚れが入り込みにくい構造、そして汚れを雨水が洗い流す構造という二段構えです。
これにより、外壁が「黒ずむ」「黄ばむ」「雨筋が目立つ」といった経年変化を抑制できます。
◎遮熱性・遮熱保持性
特に屋外環境で気になるのが、夏場の外壁の熱吸収・室内への影響。そして塗膜が汚れて熱を吸収しやすくなることで遮熱性能が落ちてしまうという点が問題となります。
プラチナリファインMF-IRでは「特殊遮熱無機顔料」を全色(標準色トゥルーホワイト除く)に使用し、近赤外線を反射する機能を付与しています。
さらに、汚れにくいため遮熱効果も長期間維持されやすく、一般的な遮熱塗料と比べて「長持ちする遮熱塗料」と言えるのです。

◎防カビ・防藻性
外壁にカビや藻が発生すると、美観を損なうだけでなく、塗膜の劣化を早め、湿気を抱えてしまうことで建材の劣化や雨漏りリスクも高めてしまいます。
プラチナリファインMF-IRでは、JISZ2911「かび抵抗性試験」および独自の藻抵抗性試験に合格しており、防カビ・防藻剤を高配合。
結果、菌種の種類にも幅広く効果を発揮し、長期にわたってカビ・藻を抑制します。
こうした機能は、湿気の多い地域、雨量の多い地域、周囲が緑や樹木の多い環境、あるいは海岸に近く塩害・潮風の影響を受けやすい地域では特に価値が高まります。

◎カラーバリエーション・対応下地幅
色数はおよそ69色(製品によって多少異なります)を展開しており、さまざまなデザイン・建物景観に合わせて選択できます。
また、対応下地素材も幅広く、窯業系サイディング・モルタル・ALC・コンクリート・金属サイディング(カラー鋼板・ガルバリウム鋼板・ステンレス・アルミニウム)・波形スレート・既塗膜までとなっています。
幅広い下地に適用できる点で、戸建てはもちろん、賃貸併合住宅・マンション外壁リニューアル・商業施設などでも検討の対象になります。
■選ぶ理由・メリット
この塗料を選ぶことで得られるメリットは以下の通りです。
1.塗り替えサイクルの長期化
期待耐用年数が20年以上という高スペックなので、次回塗り替えまでの期間を延ばせます。
これはランニングコスト・手間の軽減につながります。
2.長期間にわたる美観保持
低汚染・防藻・防カビ機能により「塗って数年後に見違えるほど汚れてしまった」というリスクを減らせます。
3.快適・省エネ空間への貢献
遮熱機能が長く維持されることで、夏場の室内温度の上昇を抑える可能性があり、冷房負荷の軽減や居住快適性の向上が期待できます。
4.信頼できる技術基盤
試験データ・第三者試験・施工実績などが公開されており、「高性能塗料」であるという裏付けが明確です。
例えば施工事例紹介でも多くの戸建てで採用実績があります。
⚠注意点・施工時のチェックポイント
ただし、どんなに性能が高くても塗料の能力を引き出せるかどうかは「施工の質」「下地の状態」「気候条件」「メンテナンス」に大きく左右されます。
以下の点をチェックしておくことが大切です。
・下地処理の適切さ:ひび割れ、浮き・剥がれ、旧塗膜の状態、水分の含有などがあると塗料の性能を十分に発揮できません。
・使用仕様・塗布量・乾燥時間の遵守:製品指定の塗布量や乾燥時間・希釈率などを守ることが重要です。
・施工店の技術・認定:プラチナシリーズは、アステックペイントが施工店を厳選しており、専門の認定を受けた施工店での施工が推奨されます。
・気候条件・環境条件の影響:施工時期(気温・温度)、建物の立地(風・日当たり・近隣の樹木・交通量)、汚染度合い(排気ガス・黄砂・海風など)によって耐久性が変わります。
・定期メンテナンス・チェック:高機能塗料であっても、完全メンテナンスフリーではありません。年月が経つにつれて塗膜のチェック・洗浄・清掃などを行うことでより長持ちに繋がります。
⸻
こんな方におすすめ
• 建物を長期間美しい状態で保ちたい方(将来売却も視野に入れている方)
• 傷み・汚れ・藻・カビが気になってきた外壁・立地条件(交通量・近隣建物)にある方
• 夏場の外壁発熱・室内温度上昇を抑えたい、快適な居住性を維持したい方
• 建物のランニングコスト(塗り替え費用・メンテナンス費用)を抑えたいと考えている方
まとめ☆彡
外壁は「家の顔」であり、住まいの第一印象だけでなく、建物の保護・構造寿命・快適性など多くの役割を担っています。だからこそ、塗料選びは慎重に行いたいもの。プラチナリファインMF‑IRは、これまでの塗料が抱えていた「汚れが付きやすい」「色あせ・劣化が早い」「遮熱効果が落ちてしまう」といった課題に対し、無機成分の緻密な塗膜・親水性・耐候性・遮熱性を備えることで応えた、進化系の外壁塗料と言えます。
もちろん、「塗れば万事解決」というわけではありません。施工前の建物診断、下地処理、施工仕様の遵守、施工店の技術力、アフターメンテナンスというトータルで考えることが、性能を実際に発揮させる鍵となるでしょう。それでも、「できるだけ長くきれいに」「できるだけメンテナンスは控えめに」という願いを叶える一手として、プラチナリファインMF‑IRは魅力的な選択肢です。
外壁塗装を考えている皆さん、この塗料があなたの大切な住まいを、これからもずっと守るパートナーになってくれるかもしれません。ぜひ、施工店としっかり話をして、現地調査・見積もり・仕様書まで確認しながら、安心・納得の塗装を進めてください。
大牟田市付近で外壁塗装・屋根塗装をご検討されている方は、是非この記事を参考にしてください!
大牟田市で外壁塗装・屋根塗装なら『リペイントラボ』へおまかせください!
リペイントラボでは、現地調査・お見積りは無料で行っておりますので
塗替えをご検討のお客様は是非ご相談ください(^^♪
最後までお読みいただきありがとうございました!
リペイントラボでは、現地調査・お見積りは無料で行っておりますので
塗替えをご検討のお客様は是非ご相談ください(^^♪
最後までお読みいただきありがとうございました!
≪事前予約がお得!!≫
リペイントラボHPよりご来店予約いただきますと
500円分のQUOカードをプレゼントしております。
是非事前のご予約をお願いいたします☆
👉Instagramも更新中✨是非フォローお願いします🙆♀️
★大牟田市・荒尾市・みやま市・柳川市の外壁塗装はリペイントラボへ★
◆リペイントラボのこだわり◆
その① 長持ち塗装
塗替えは下地と塗料の密着が非常に重要!経験豊富なスタッフが現地調査を行い適正な材料を選択いたします。
その② シーリング工事
最新の高耐久性シーリング剤を使用。3~5日の十分な乾燥時間を設けた上で塗装することで高耐久性を実現します。
その③ 3回塗り
強い塗膜を形成するため、手塗りのローラー工法で丁寧に施工します。
▶大牟田市の外壁塗装・屋根工事等3,000件以上のBefore&Afterはこちら
▶ショールーム来店予約はこちら
★大牟田市・荒尾市・みやま市・柳川市の外壁塗装はリペイントラボへ★